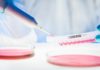
Meta-Analysis in Healthcare Research

Problems
In this digitalized world, we are producing a huge amount of data every minute. The amount of data produced in every minute makes it challenging to store, manage, utilize, and analyze it.
Even large business enterprises are struggling to find out the ways to make this huge amount of data usage. Simply storing this huge amount of data is not going to be all that useful and this is the reason why organizations are looking at options like data lakes and big data analysis tools that can help them in handling big data to a great extent.
Some challenges faced in Big Data analysis are Handling voluminous data, Shortage of data scientists, Velocity challenges in real time, getting real-time Insights, Data Governance, and Security, that make it Expensive also have Too many options in Bigdata, and lastly Troubles of upscaling’s.
Solutions
Handling voluminous data can be easy with the help of different tools we expertise in like: -Hadoop is great for managing massive volumes of structured, semi-structured unstructured data. Visualization is another way to perform analyses, Robust Hardware makes it easier to handle volume problems. Platforms like Spark use model plus in-memory computing to create huge performance gains for high volume and diversified data.
We have experienced and capable data scientist which can help you in implementing technology in the analysis.
To handle Velocity challenges in real time Flash memory is needed for caching data, especially in dynamic solutions that can parse that data as either hot (highly accessed data) or cold (rarely accessed data). Transactional databases, expanding private cloud using a hybrid model and sampling the process. Hybrid SAAS/PAAS/LAAS systems along with cloud computation and storage can greatly
solve the velocity problem but at the same time, we should take care of security and privacy of data.
To get the real-time Insights the idea here is that you need to create a proper system of factors and data sources, whose analysis will bring the needed insights, and ensure that nothing falls out of scope. Such a system should often include external sources, even if it may be difficult to obtain and analyze external data.
For data security Examine your cloud providers, all stages of data should be encryption to ensure no sensitive data is leaked, acquire real-time security monitoring, restrict access to the data by adding certification or access control to the data entries. We need to develop and design secured certification or access control mechanisms. Inject randomness into the data to ensure that it satisfies all the privacy goals.
Big data, optimization, and implementation into the enterprise can be expensive you have to upgrade your hardware, software and training your staff outsourcing the service is the right step.
You could hire us for Options in big data. With joint efforts, you’ll be able to work out a strategy and, based on that, choose the needed technology stack like. There are also hybrid solutions when parts of data are stored and processed in cloud and parts – on-premises, which can also be cost-effective. And resorting to data lakes or algorithm optimizations (if done properly) can also save money:
1. Data lakes can provide cheap storage opportunities for the data you don’t need to analyze at the moment.
2. Optimized algorithms, in their turn, can reduce computing power consumption by 5 to 100 times. Or even more.
For upscaling a decent architecture of your big data solution. As long as your big data solution can boast such a thing, fewer problems are likely to occur later. Another highly important thing to do is designing your big data algorithms while keeping future upscaling in mind. you also need to plan for your system’s maintenance and support so that any changes related to data growth are properly attended to. And on top of that, holding systematic performance audits can help identify weak spots and timely address them.
Our Expertise
We can resolve the variety of problems using ETL tools, visualization tools, and OLAP tools and by having a robust infrastructure. It is hard to say just one among them could solely resolve the problem or more than one is needed or there could be some algorithm which could synchronize the data varieties in a uniform format, it depends on particular case or problem.
Experience with relational and non -relational database systems is a must. Examples Mysql, Oracle, DB2 and HBase, HDFS, MongoDB, CouchDB, Cassandra, Teradata, etc.
We have flawless:
- understanding and familiarity with frameworks such as Apache Spark, Apache Storm, Apache Samza, Apache Flink and the classic MapReduce and Hadoop.
- Command over programming Languages like– R, Python, Java, C++, Ruby, SQL, Hive, SAS, SPSS, MATLAB, Weka, Julia, Scala. As you can not knowing a language should not be a barrier for a big data scientist
- IT infrastructure greatly enhances Big Data implementation
- Business Knowledge of domain.
Our Services Include:
- Scalability: We need to take care of the storage capacity and the computing power to enhance scalability.
- Availability for 24 hours
- Performance
- Tailored, flexible and pragmatic solutions
- Full transparency
- High-quality documentation
- A healthy balance between speed and accuracy
- A team of experienced quantitative profiles
- Privacy
- Fair pricing
Technology Stack:
Big Data Tools and Technologies
- Big Data Processing Tools: Hadoop distributed file system (HDFS) and a number of related components such as Apache, Hive, HBase, Oozie, Pig, and Zookeeper and these components are explained as below:
- HDFS: A highly faults tolerant distributed file system that is responsible for storing data on the clusters.
- MapReduce: It is a parallel programming technique for distributed processing of huge amount of data on clusters.
- HBase: A column-oriented distributed NoSQL database for random read/write access.
- Pig: A high-level data programming language for analyzing data of Hadoop computation.
- Hive: A data warehousing application that provides SQL-like access and the relational model.
- Sqoop: A project for transferring/importing data between relational databases and Hadoop.
- Oozie: An orchestration and workflow management for dependent Hadoop jobs.
- Big Data Analysis Tools
- Hadoop and MapReduce
It is a programming model for processing massive datasets and works on the principle of divide and conquer. It provides scalable and commercial machine learning techniques for big data and smart data analysis. Clustering, classification, pattern mining, regression, dimensionality reduction, evolutionary algorithms, and batch based collaborative filtering are core algorithms of the mahout. Apache Mahout is to provide a tool for attenuating big challenges. - Apache Spark
It is a framework that provides speed processing, and sophisticated analytics. It lets us write applications in Java, Scala, or python. It consists of three components which are driver program, cluster manager, and worker nodes. It supports iterative computation, enhances speed and does better resource utilization. - Dryad
It is a programming model for executing parallel and distributed programs for managing large databases. It has a cluster of computing nodes. It is an infrastructure for running data-parallel programs. Dryad uses various machines with different and several processors and performs concurrent programming. - Storm
It a distributed and computation system for processing unbounded streaming data. It is designed for real-time processing instead of batch processing. It is very handy and easy to operate and has great performance. It is a free and open source distributed real-time computation system. - Apache Drill
It is a distributed system for interactive analysis of big data. It supports many query languages, several data formats. It is specifically for exploiting nested data. - Jaspersoft
It is open source software that is mainly for producing reports from database columns. It’s basically an analytical platform and provides data visualization for storage platforms, including MongoDB, Cassandra, and much more. - Splunk
It is a real-time and smart platform created for making the best use of machine-generated big data. It merges the up-to-the-moment cloud technologies and big data very swiftly and easily. It provides a web interface to help users monitor their machine-generated data.
- Hadoop and MapReduce